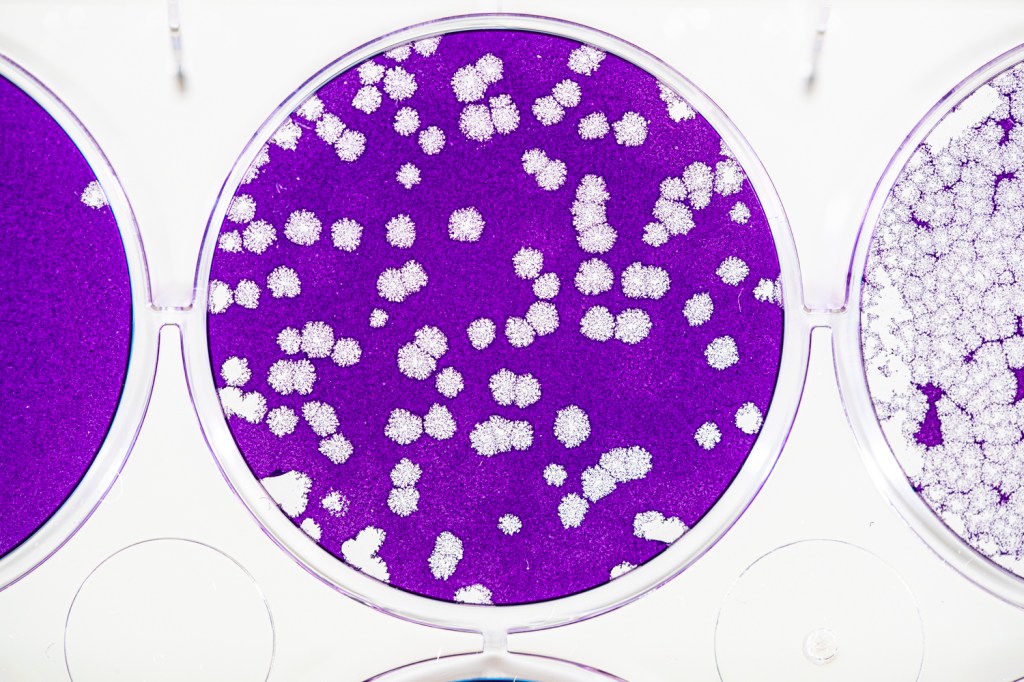

I am well-aware that I’m not unique in saying that life after mid-March 2020 has been, to use the word of the moment, unprecedented. There’s no reason to recap the past few months, we’ve all lived through it: the shutdown, the partial reopening, the partial shutdown, the transformation of education, work and our cities. You get it.
I’ve been a history lover since as long as I can remember, and while my favorite historians are adept at using primary documents to create historical narratives and trends that mark major moments of disruption and social change, I’ve always thought the books that rise to the top are the ones that capture the persistent normalcy of everyday life during turbulent times. One such example comes from Daring to Look by Anne Whiston Spirn, a biography of famed photographer Dorothea Lange and visual history of the Great Depression. In it, Spirn includes many of Lange’s diary entries as she photographed migrant workers across the country, with many entries being surprisingly upbeat or funny or simply observational, even as she’s documenting one of the bleakest times in American history. I think when we read and think about negative historical moments like the Great Depression we tend to forget that there was still joy and laughter and hope.
It’s hard not to compare the impact of the COVID Era (I hope historians will decide on a better moniker) to the Great Depression. Somehow my generation has been lucky enough in our young lives to experience three massive historical moments—9/11, the Great Recession and, now, COVID—that have and will impact the rest of our lives.
During these months of strict quarantine in Chicago, I obviously haven’t been able to photograph as I usually do, and that’s been an extraordinarily weird thing for me that I still am not really able to articulate. It’s been exhausting to not be able to create, to have my schedule totally blown up and obviously be in the very precarious position of being a photographer in an age when it seems like no one wants to pay for or respect art anymore. But last week I was finally able to have a mostly normal photography day, and it was wonderful. It was a reminder that I can be good at what I do on occasion, and that even in this depressing time it is sometimes the brief return to normalcy that is all we really need to feel good.

Dr. Susan Baker is a virologist who has been studying virus transmission for over 30 years, which is obviously relevant at the moment. When I met her in her lab last week, she was cheerful and extraordinarily giving of her time as I fumbled around with my equipment that I haven’t been able to use nearly as often as I’m used to. And unlike most researchers/professors I photograph, she totally understood the look I was going for with the color scheme. For someone who is doing as important work as she is, it felt truly ridiculous that I took hours of her and her students’ time for photos—but at least they were all enthusiastic about the whole process!

We’re still in the beginning stages of this pandemic and who knows where it’s going, but maybe when I look back at this historical time period, I’ll be able to see it like Lange did on some days during the Great Depression—it was bad (to use an oversimplified word), but there was still some joy and laughter and hope.